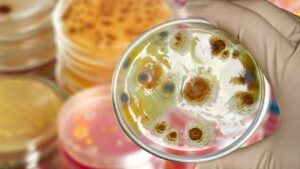

Crnonožna mačka, koja živi u samo tri zemlje južne Afrike (Namibiji, Južnoj…
10.06. u 10:23 / Zabava, Zanimljivosti
Dolazak životinje u vaš dom prema vjerovanju mnogih kultura i naroda nije…
19.05. u 12:05 / Zabava, Zanimljivosti
Mačke su jedna od najzagonetnijih stvorenja koja su kroz historiju intrigirala ljudsku…
05.05. u 20:20 / Zabava, Zanimljivosti
U narodu vlada mišljenje da crna mačka donosi nesreću, međutim to nije…
09.08. u 14:30 / Zabava, Zanimljivosti
10.06. u 10:23 / Zabava, Zanimljivosti
19.05. u 12:05 / Zabava, Zanimljivosti
05.05. u 20:20 / Zabava, Zanimljivosti
09.08. u 14:30 / Zabava, Zanimljivosti